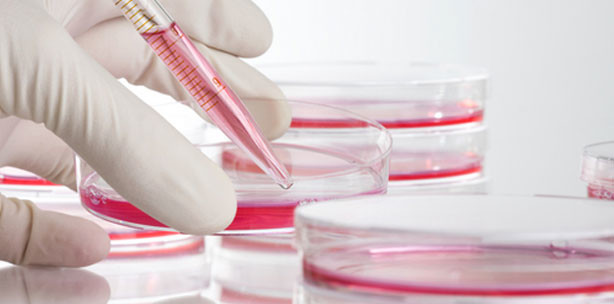
EHEC: Wissenschaftler bestimmen Genomsequenz

Wissenschaft und Forschung 07.06.2011
EHEC: Wissenschaftler bestimmen Genomsequenz
Die Genomsequenzierung eines Vergleichstammes aus dem Jahr
2001 zum nötigen Abgleich mit dem aktuellen E. coli HUSEC041-Ausbruchsstamm wurde am 5. Juni 2011 von Wissenschaftlern der Medizinischen Fakultät der
Westfälischen Wilhelms-Universität (WWU) Münster und des
Universitätsklinikums Münster (UKM) abgeschlossen. Durch den Vergleich
der beiden Datensätze erhofft sich das Wissenschaftlerteam unter der
Leitung von Prof. Dr. Dr. h.c. Helge Karch, dem Direktor des Instituts
für Hygiene in Münster, wertvolle Hinweise darüber, was den aktuellen
Ausbruchsstamm so aggressiv macht.
Bereits am 25. Mai konnten die Forscher aus Münster HUSEC041
als den aktuellen Ausbruchsstamm identifizieren. Bei den aktuell
laufenden Untersuchungen steht die Frage im Mittelpunkt, warum und in
welcher exakten Form sich dieser Stamm gegenüber den zehn Jahre alten
Isolaten verändert hat. So verfügt der aktuelle Ausbruchsstamm etwa über
eine neue Antibiotikaresistenz. Der Stamm ist nicht neu, sondern
bereits früher aufgetreten, allerdings extrem selten. Bei dieser
Fragestellung arbeiten Wissenschaftler verschiedener Einrichtungen der
Medizinischen Fakultät Münster und des Universitätsklinikums Münster eng
zusammen.
Der Mikrobiologie Prof. Dr. Dag Harmsen leitet das Sequenzierteam in
Münster. Der Forschungsleiter der Poliklinik für Parodontologie in
Münster erläutert das aktuelle Vorgehen: „Unsere Mitarbeiter haben
Proben, die den aktuellen Stamm aus 2011 enthalten, an Wissenschaftler
des Unternehmens „Life Technologies Corporation“ in Darmstadt
übermittelt, die das Genom dieses Stamms sequenziert haben. Nun haben
wir in Rekordzeit innerhalb von drei Tagen die Genomsequenz des
Vergleichsstamms aus dem Jahr 2001 davon unabhängig in unseren
Laboratorien hier in Münster entziffert.“ Eine solche schnelle
Sequenzierung sei eine „wissenschaftliche Meisterleistung, die einen
weiteren Beitrag zum besseren Verständnis des aktuellen Ausbruchs und
damit eventuell in einem nächsten Schritt des teilweise sehr schweren
Krankheitsverlaufs bei den betroffenen Patienten liefern kann“, erklärt
Prof. Dr. Wilhelm Schmitz, Dekan der Medizinischen Fakultät der
Universität Münster.
Nun gelte es, die vorliegenden Ergebnisse der beiden Sequenzierungen im
Vergleich sorgfältig und exakt zu analysieren, betont Prof. Harmsen:
„Zunächst haben wir nun nur die Buchstaben bestimmt. Um die Wörter oder
gar das Buch des Genoms zu verstehen, bedarf es in der nun mit Hochdruck
laufenden Analyse sowohl großen biologischen als auch bioinformatischen
Sachverstandes. Diese Analyse muss dann die Grundlage für die weiteren
Schritte sein.“
„Zum jetzigen Zeitpunkt erwarten wir allerdings noch keine unmittelbar
diagnostisch oder gar therapeutisch verwertbaren Ergebnisse aus der
Analyse. Jedoch erhoffen wir uns durch den Vergleich beider
Genomsequenzen wertvolle Hinweise darüber, was den aktuellen
Ausbruchsstamm so aggressiv macht“, so Dr. Alexander Mellmann vom
Nationalen Konsiliarlabor für das Hämolytisch–urämische Syndrom (HUS)
des Robert Koch-Institutes am Institut für Hygiene in Münster.
Parallel zu diesen Arbeiten werden in Münster unter der Leitung von
Prof. Dr. Dr. h.c. Helge Karch weitere Untersuchungen zum besseren
Verständnis und zum biologischen Verhalten des aktuellen Ausbruchsstamms
durchgeführt: Hier stehen Fragen zur bereits festgestellten
Antiobiotikaresistenz oder zu seinem Verhalten unter speziellen
Umweltbedingungen im Vordergrund. Ziel dabei ist es, wertvolle Hinweise
zu seinem natürlichen Reservoir zu finden. „Diese Fragen sind wichtig,
um den Erreger nach dem endgültigem Auffinden der Infektionsquelle und
seinem Reservoir wieder aus der Umwelt entfernen zu können. Denn unser
Ziel ist es auch, weitere Ausbrüche in der Zukunft zu vermeiden“, so
Prof. Karch.
Quelle: idw-online, Universitätsklinikum Münster